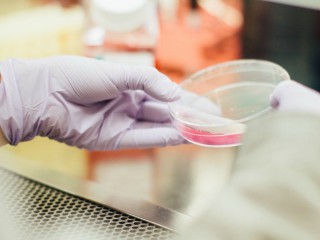

Liliecii au mereu greutatea ideeala
5/12
Digestia liliecilor este foarte rapida, intre 20 si 60 de minute cel mult, ceea ce ii ajuta sa isi pastreze greutatea mica pentru a zbura mereu, fara probleme. Au un metabolism de invidiat, putand digera totul intr-un timp foarte scurt.

Nu imbolnavesc oamenii asa cum se crede
6/12
De altfel, liliecii evita atat cat pot sa fie in prezenta oamenilor. In doar 50 de ani, mai putin de 10 persoane au contractat rabie de la lilieci - s-a promovat in cultura ideea ca aceste animale poarte diverse boli si toxine. Totusi, ca masura de precautie, se recomanda ca daca esti muscat de un liliac, sa contactezi un doctor, sfatuieste
nature.org.

Cat traiesc liliecii?
7/12
Liliecii pot ajunge sa aiba o durata de viata de pana la 30 de ani. Probabil si pentru ca se descurca extrem de simplu sa isi procure hrana, chiar si in bezna totala: localizeaza insecte in baza sunetelor si asculta ecourile lor (pot manca pana la 1.200 de tantari in doar o ora; uneori consuma o cantitate de insecte echivalenta cu greutatea corpului lor, doar intr-o noapte).

Specii in pericol de extinctie - liliecii
8/12
Mai mult de jumatate dintre speciile de lilieci sunt amenintate cu disparitia sau listate ca fiind in pericol de extinctie. Pe langa faptul ca sunt lipsiti de habitatul natural, gratie interventiilor umane, acestia sunt afectati de un sindrom (
white nose syndrom) care pana in 2018, doar in SUA si Canada, a dus la moartea a peste un milion de lilieci.

Unii lilieci migreaza catre sud in timpul iernii, in timp ce altii hiberneaza timp de luni intregi - acestia pot supravietui chiar si la temperaturi de inghet sau daca au fost prinsi in gheata.

Isi recunosc puii intr-o aglomerare de milioane de lilieci
10/12
Cele mai multe specii de lilieci pot avea sezonul de imperechere doar o data pe an - un alt lucru care contribuie la vulnerabilitatea lor in fata pericolului de extinctie. Un lucru foarte interesant pentru perpetuarea speciei este faptul ca femelele mame isi recunosc puii dintr-o gramada de lilieci in baza vocii unice si a mirosului specific lor.

Liliecii nu sunt chiar orbi
1/12
Doar cele mai mici specii de lilieci se folosesc de ecolocatie pentru a se orienta in spatiu. Liliecii mai mari au vederea chiar mai buna decat multi oameni - totusi, asta nu ii ajuta mereu, pentru ca tocmai faptul ca vad atat de bine ii poate dezorienta.

Excrementele de liliac, extrem de folositoare
1/12
Excrementele de liliac se extrag sub forma de guano din pesteri si se folosesc ulterior, ca ingredient principal pentru ingrasaminte naturale. Reprezinta unul dintre cele mai bogate fertilizatoare naturale (bogate in azotat de potasiu) pentru pamant. In urma cu multi ani era o adevarata afacere dezvoltata pe seama lor. Guano se mai poate folosi si pentru a se face praf de pusca sau diverse explozibile.

Cel mai mic si cel mai mare liliac
1/12
Cei mai mari lilieci sunt cei din specii de megachiroptere, genul pteropus si liliacul regal putand cantari pana la un kilogram si jumatate. Cel mai mare liliac din lume este Flying Fox si traieste in insulele din sudul Oceanului Pacific, ajungand ca dimensiuni de aripi de pana la 1.80 metri. Cel mai mic liliac este cunoscut ca bumble bee (liliacul bondar sau liliacul cu cap de porc) din Thailanda si este mai mic decat buricul unui deget, cantarind mai putin decat o moneda.

Nu toti liliecii dorm cu capul atarnat
2/12
In principiu cam asa dorm liliecii - atarnand in jos, pana ca si picioarele sa fi evoluat cat sa stea cat mai relaxate in aceasta pozitie. Atunci cand se pregatesc de zbor, pur si simplu isi dau drumul, facand ascensiunea indata. Totusi, exista sase specii care nu aleg pozitia asta, noteaza
howstuffworks.

Liliecii sunt singurele mamifere care pot zbura
3/12
Cu abilitati extraordinare de zbor, liliecii au aripi subtiri, ceea ce le permite sa faca ceea ce se numeste "profil aerodinamic" si sa inainteze cu propulsie puternica. Ca orice mamifer, femelele isi hranesc puii cu lapte.

Exista lilieci vampiri care se hranesc cu sange
4/12
Doar ca nu sunt Dracula, nu se transforma si cu siguranta nu traiesc in sicrie. La nivel global exista doar trei lilieci vampiri care se hranesc cu sange, dar nu il sug, cel mult musca un animal si ling sangele. De altfel, unii pot actiona si ca polenizatori pentru natura.
Liliecii numara peste 1.100 de specii la nivel global, fiind mamifere care au membrele anterioare ca aripi, acoperite cu o membrana subtire. Cu diverse superstitii tesute in jurul lor, liliecii sunt, in diverse culturi, semn rau si adesea asociati cu vrajitoria sau moartea. Conform oamenilor de stiinta, liliecii sunt prezenti pe planeta de milioane de ani, cu mult inainte ca oamenii sa-si revendice drepturile. Iata ce secrete ascund liliecii si ce anume face ca aceste animale sa fie atat de speciale.